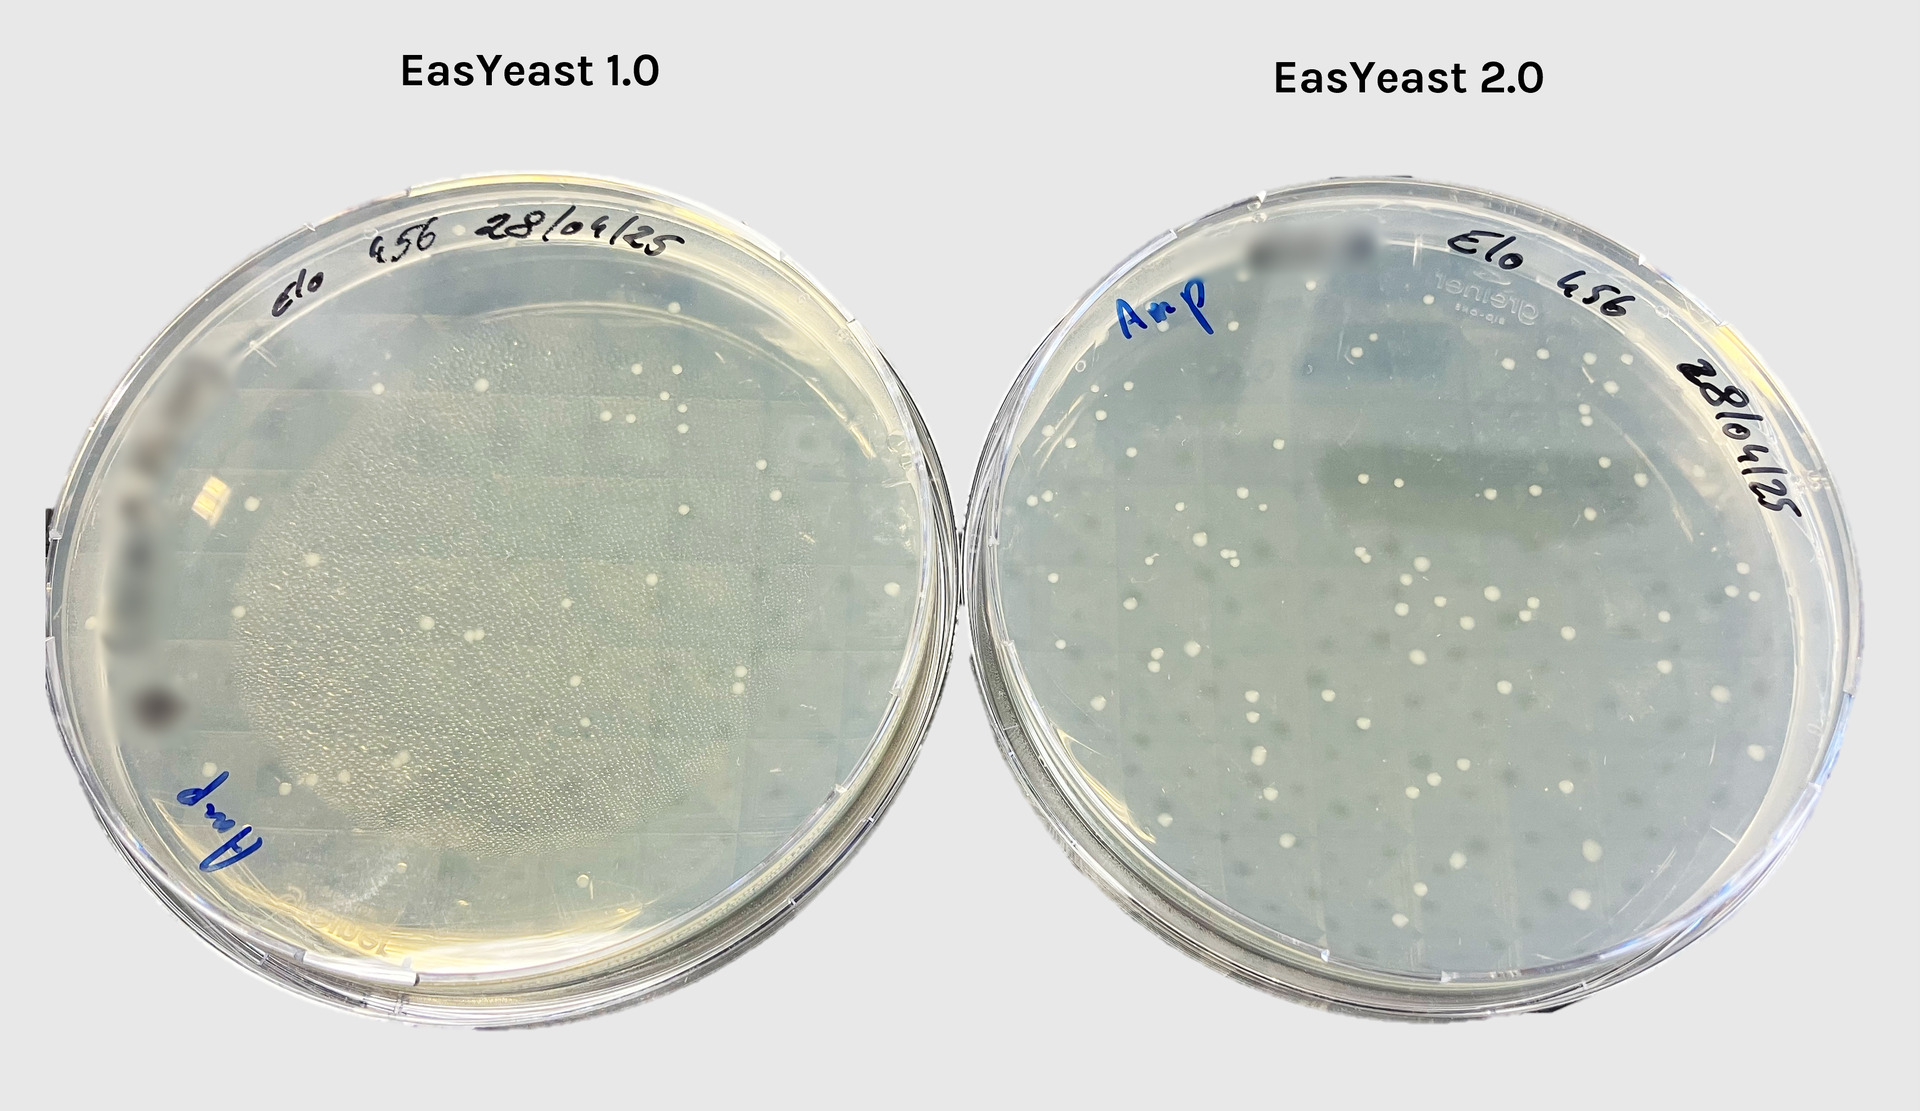

EasYeast - Yeast DNA extraction
Quick method for yeast DNA extraction
New version available !
Discover EasYeast 2.0, delivering twice the yield of extracted DNA for ultra-efficient extraction workflows
A technology developed by Jean-Luc Evrard (IBMP, CNRS, France)
Your Dynamic Snippet will be displayed here...
This message is displayed because youy did not provide both a filter and a template to use.